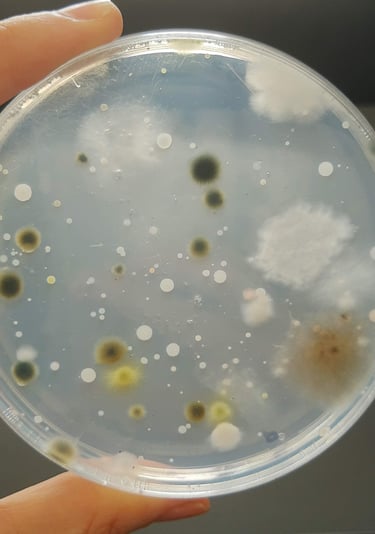
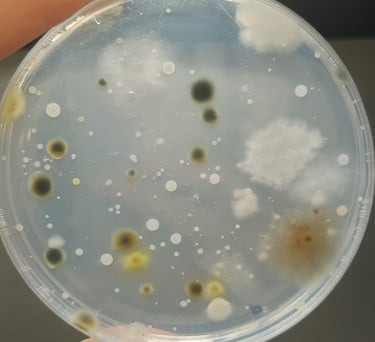

Agendá tu llamada de claridad gratuita
Elegí el día y horario que mejor te quede.
Recibirás la confirmación automática en tu email.






Con la Dra. Laura Boiero · 20 minutos · Por videollamada · Sin costo
Elegí el día y horario que mejor te quede.
Recibirás la confirmación automática en tu email.

Con la Dra. Laura Boiero · 20 minutos · Por videollamada · Sin costo
